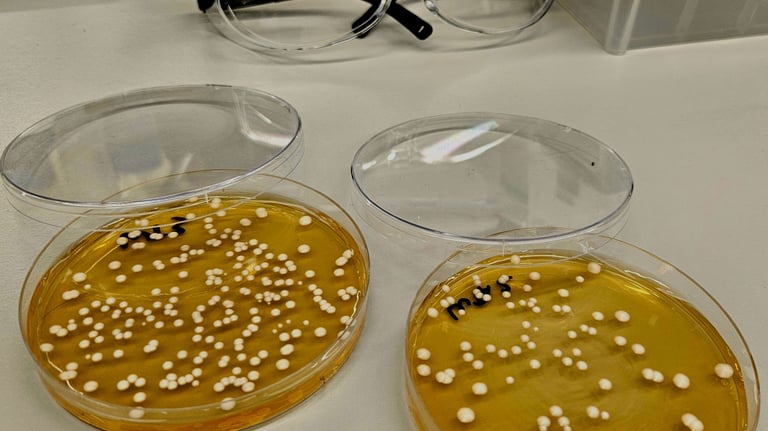
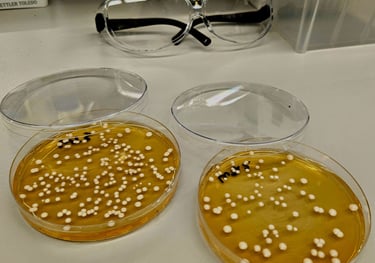

Learning builds on what we already know. By observing, questioning, and connecting new ideas to familiar ones, kids strengthen their understanding of how the living world works. This section offers experiment ideas, lessons, and simple protocols that help teachers and parents guide students through the core concepts of genetics, biology, and biochemistry. Each activity encourages curiosity, critical thinking, and hands-on exploration—so learners can discover foundational science one observation at a time.